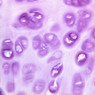
bone

You are here: Medical Histology>Main Web>AtlasContents>CartilageAndBoneAtlas08 (20 Jun 2015, LorenEvey)Edit Attach
Chapter Eight: Cartilage and Bone
Introduction
In both structure and function, cartilage and bone are closely related. Most of the bone in the body develops from a type of cartilage. In both of these supporting tissues, cells and fibers are prominent. The special rigidity, however, of the matrices is the quality that distinguishes these from the other connective tissues and underlies their supportive functions. Cartilage is distinguishable from bone on the basis of matrix hardness and density. Further, cartilage is avascular, whereas bone is well permeated by blood vessels. Prior to learning the microarchitecture of Cartilage and Bone, use the table below to review some of the gross anatomy of these tissues:| Structure | Image |
|---|---|
| Cartilage Symphysis | |
| Rib Cage | |
| Vertebrae | |
| Skull | |
| Skull Dissected | |
| Humerus (Inside) | |
| Synovium | |
Cartilage
There are three types of cartilage which traditionally have been distinguished on the basis of matrix characteristics. These are: 1) hyaline cartilage, 2) elastic cartilage, and 3) fibrocartilage.Hyaline Cartilage
Hyaline cartilage forms an incomplete ring in the wall of the trachea (slide slide A-72, PAS [2.5x, 10x-labeled, 20x, 40x-labeled] [2.5x, 10x, 20x, 40x]; A-75, H&E [2.5x, 10x, 20x-labeled, 40x] [2.5x, 10x, 20x, 40x]; A-76, H&E [2.5x, 10x, 20x, 40x] [20x, 40x]). The ring of cartilage is bound on its inner and outer sides by a dense fibro-cellular membrane called perichondrium. The perichondrium has an outer fibrous and inner chondrogenic (cellular) layer. These layers are discernable when cartilage is actively growing (A-6, infant costal cartilage, H&E [2.5x, 10x, 20x, 40x-labeled] [2.5x, 10x, 20x, 40x]; A-6, aniline blue [2.5x, 10x, 20x, 40x]). Cartilage grows when cells (chondroblasts) within this membrane deposit new ground substance. The perichondrium is also the means by which ligaments and tendons are attached to the cartilage. Cells inside the cartilage substance are called chondrocytes; they are enveloped by the semi-solid matrix which appears to be fibrillar. In sections the cells have usually shrunk away slightly from the matrix, exaggerating the lacuna or space in which they lie. Where several cells appear clumped together, they are called cell nests. These nests result from multiplication of chondrocytes which have thereafter been unable to move apart. Scanning the section will show that the matrix has differences in coloration from one place to another, reflecting differences in chemical constitution. The ground substance of the hyaline cartilage consists of three types of glycosaminoglycans: hyaluronic acid, chondroitin sulfate, and keratin sulfate. These components are not uniformly distributed through the matrix. Due to the presence of sulfate groups, these proteoglycans stain with basic dyes. Their highest concentrations are immediately around the lacuna. This area of intense staining is referred to as the capsule. Concentrations of the proteoglycans are somewhat less in matrix areas outside the capsule. In hyaline cartilage matrix, the fibers are inconspicuous. These fibers are collagen (type II) and are arranged in a felt-like three-dimensional network. In the fetal finger (slide A-12 [2.5x, 10x, 20x, 40x] [10x, 20x]) hyaline cartilage serves as a template for endochondral bone formation. Look at the tarsals. Use this slide to distinguish between appositional growth and interstitial growth of cartilage. Isogenous groups of chondrocytes are several chondrocytes clustered together into a group. These cells are the progeny of a single chondrocyte. This is indicative of interstitial growth. Appositional growth occurs by mitosis in the chondrogenic layer of the perichondrium.Hyaline Cartilage Image Gallery
Hyaline Cartilage Table of Identifications
| Row | Structure | Abbreviation | Optimal Stain | Representative Section | Note |
|---|---|---|---|---|---|
| 1 | Dense Connective Tissue | DCT | PAS | |
|
| 2 | Perichondrium | P | PAS | |
|
| 3 | Growing Cartilage | GC | PAS | |
|
| 4 | Chondroblast | Cb | PAS | |
|
| 5 | Mature Chondrocyte | C | PAS | |
|
| 6 | Chondrocyte Nucleus | (none) | PAS | |
|
| 7 | Lacuna | (none) | PAS | |
|
| 8 | Cell Nest (Isogenous Group) | (none) | PAS | |
|
| 9 | Ground Substance | (none) | PAS | |
|
| 10 | Hyaline Cartilage | (none) | H&E | |
|
| 11 | Pseudostratified Columnar Epithelium | (none) | H&E | |
|
| 12 | Fibroblast | (none) | H&E | |
|
| 13 | Formative Chondrocyte | (none) | H&E | |
|
| 14 | Fibrous Perichondrium | Pf | H&E | |
|
| 15 | Cellular Perichondrium | Pc | H&E | |
Top of page
Elastic Cartilage
Elastic cartilage (A-51, H&E [2.5x, 10x, 20x, 40x]; A-51, Verhoeff stained for elastic fibers [2.5x, 10x, 20x, 40x] [2.5x, 10x, 20x, 40x]) is similar to hyaline cartilage, but with elastic fibers in the matrix. Verhoeff's stain is specific for elastic fibers. Other features of this tissue resemble hyaline cartilage: perichondrium, lacunae with chondrocytes, and matrix basophilia. Note the absence of blood vessels in the cartilage. In H&E stained tissue, the elastic fibers cannot be visualized. Where can elastic cartilage be found?Elastic Cartilage Image Gallery
Top of page
Fibrocartilage
Fibrocartilage (A-3, H&E [2.5x-labeled, 10x, 20x, 40x-labeled] [2.5x, 10x, 20x, 40x]). Examine the section of tissue from the intervertebral disc. This tissue is fibrocartilage, the least abundant form of cartilage. Fibrocartilage appears as small nests of chondrocytes embedded in a fibrous connective tissue. It is found where cartilage is subject to pressure, (i.e., intervertebral discs). This type of cartilage occurs as a transition between tendon and bone and perhaps for this reason it does not have a perichondrium. Only the rounded lacunae show clearly that this tissue is cartilage. As with the other types of cartilage, chondrocytes produce and maintain the extracellular matrix. Matrix with a higher concentration of proteoglycans, indicated with darker staining, can be seen immediately around the lacunae—territorial matrix. Areas with a lower concentration of proteoglycans stain less intensely—interterritorial matrix.Fibrocartilage Image Gallery
Fibrocartilage Table of Identifications
| Row | Structure | Abbreviation | Optimal Stain | Representative Section | Note |
|---|---|---|---|---|---|
| 1 | Intervertebral Disk | (none) | H&E | |
|
| 2 | Fibrocartilage | (none ) | H&E | |
|
| 3 | Bone | (none) | H&E | |
|
| 4 | Bone Marrow | (none) | H&E | |
|
| 5 | Chondrocyte | C | H&E | |
|
| 6 | Lacuna | L | H&E | |
|
| 7 | Fibroblast | F | H&E | |
|
| 8 | Interterritorial Matrix | IM | H&E | |
|
| 9 | Territorial Matrix | TM | H&E | |
Top of page
Bone
Bone is a specialized connective tissue. The cells are osteoblasts (which form bone), osteocytes (the cells in lacunae with long processes), and osteoclasts (bone resorbing cells). Bone is vascular and dynamic with constant resorption and formation of bone tissue. Unlike the chondrocytes which are prisoners in their lacunae for life, osteocytes are periodically freed from their lacunae by a remodeling process. Osteocytes have processes which extend to the perivascular space to bring in nutrients. Bone has a periosteum which acts similar to cartilage's perichondrium. The periosteum has 2 layers; an outer fibrous layer and inner osteogenic layer. Sharpey's fibers or perforating fibers enter the bone matrix obliquely from the periosteum. Collagen makes up 90% of the organic matrix of bone. Whereas 60-75% of bone is the inorganic matrix in the form of calcium phosphate laid down in the fibers as hydroxyapatite crystals. This combination of collagen fibers and the calcium phosphate are like using straw in clay to make bricks. This gives bone great strength with resistance to breakage or deformation. Bone is grossly divided into compact and spongy (trabecular). Compact bone is very dense, e.g., the walls of the shafts of long bones. Spongy bone is made of a fine meshwork of spicules of bone (called trabeculae). These are found inside the shafts of bones. The spaces between the spicules are filled with bone marrow. Compact bone is vascularized via Haversian systems. Vessels enter from the external aspect of the bone and pass into the bone in Volkman's canals. They give off vessels to the Haversian systems. Volkman canals are not surrounded by concentric lamellae of bone which are characteristically seen in the Haversian system. The Haversian system is made of the Haversian canal for the blood vessels and nerves and concentric lamellae of bone separating layers of lacunae (containing osteocytes) which have fine canaliculi connecting the lacunae to the Haversian canal. These highly ordered arrays of collagen fibrils are responsible for the birefrigence (double refraction) of bone in concentric lamellae. Compact bone, (slide A-1, human ground bone [2.5x, 10x, 20x-labeled, 40x] [2.5x, 10x-labeled, 20x, 20x]) shows a cross section of ground bone. The slide mount is very thick and you may not be able to focus using your 40x objective. It is prepared by grinding down a thin piece of bone until it can be viewed under the microscope. The Haversian system can be clearly seen in this type of preparation. The lamellae are indicated by the concentric layers of dark lentiform lacunae. Canaliculi are thin threads running from the lacuna of one lamella to the lacunae of adjacent lamellae. The complex of osteocytes embedded in concentric rings (lamellae) of bone around Haversian canals forms an osteon, a structural unit of compact bone. Between osteons occur clusters of osteocytes not concentrically oriented around a canal. These clusters form interstitial lamellae, remnants of earlier osteons. At the outer and inner edges of a bony shaft, lamellae usually parallel the periosteum and endosteum, forming circumferential lamellae. In living bone, blood vessels which penetrate the bony shaft from the vascular periosteum or connect parallel Haversian canals cross the bone at an angle and are not surrounded by bony rings. These oblique canals are visible in dried bone and are known as Volkmann's canals. Note that in this section of dried bone the soft tissues, for example, cells, blood vessels, and periosteal tissue, are not represented. Only the insoluble matrix of the bone resists drying and thus can be ground into thin sections. Cement lines are refractile lines separating the individual osteons. Can you identify the interstitial systems which are partial osteons? These are seen as irregular Haversian systems between the complete Haversian systems. Can you identify any Volkman's canals? Decalcified bone is present in slide slide A-3 (intervertebral disk, H&E [2.5x, 10x-labeled, 20x, 40x] [2.5x, 10x, 20x, 40x] [2.5x, 10x, 20x-labeled, 40x, 40x]). This process enables us to visualize the cellular elements of bone. Each bone cell or osteocyte, as in cartilage, lies in a lacuna, but bony lacunae are irregularly shaped due to the radiating canaliculi through which cell processes of osteocytes make contact with each other. An impression of the density of bone matrix and the irregular shape of encased osteocytes due to their surface processes can be gained by an electron micrograph of mineralized bone. Because of the matrix density, nutrient substances pass from the Haversian canals to each osteocyte through a series of lacunae and canaliculi. The endosteum is represented by a single layer of thin flat nuclei on the surface of the marrow cavity. Identify the osteocytes and their cell processes in the canaliculi. Look for the outer circumferential lamellae adjacent to the periosteum. Can you see any inner circumferential lamellae adjacent to the endosteum?Bone Image Gallery
Bone Table of Identifications
| Row | Structure | Abbreviation | Optimal Stain | Representative Section | Note |
|---|---|---|---|---|---|
| 1 | Haversian Canal | HC | Ground | |
|
| 2 | Interstitial Lamellae | IL | Ground | |
|
| 3 | Osteocyte Lacuna | L | Ground | |
|
| 4 | Osteon | O | Ground | |
|
| 5 | Volkmann's Canal | VC | Ground | |
|
| 6 | Trabecular Bone | (none) | H&E | |
|
| 7 | Marrow | (none) | H&E | |
|
| 8 | Endosteum | (none) | H&E | |
|
| 9 | Endosteal Cell | (none) | H&E | |
|
| 10 | Osteocyte | (none) | H&E | |
Top of page
Bone Formation
There are two types of bone formation: Intramembranous (flat bones of the skull, clavical) and Intracartilagenous (endochondral or enchondral).Intramembranous Bone Formation.
In intramembranous osteogenesis, bone is formed via the initial differentiation of mesenchymal cells into osteoblasts and the subsequent deposition of osteoid and calcium salts in the mesenchymal matrix. The early aggregated nature of the mesenchymal cells/osteoblasts somewhat resembles a "membrane," hence the term intramembranous osteogenesis (A-15, fetal skull [2.5x-labeled, 10x, 20x, 40x-labeled] [2.5x-labeled, 10x, 20x, 40x]). Membranous osteogenesis occurs principally in bones of the cranial vault and face. The earliest stages of membranous ossification cannot be seen on this slide. The processes, however, are very much the same: regions of cellular embryonic connective tissue become recognizable as bony spicules when fibers and rigid matrix are deposited and enclose the connective tissue cells - osteoblasts. Spicules grow together and around blood vessels, periosteum forms on the surfaces of the spicules, and the condition seen in the fetal head is achieved. In slide A-15, the spicules and fragments have become interconnected by growth. The young decalcified bone is surrounded by a layer of embryonic fibrous connective tissue. The formed bone is somewhat similar to spongy bone. It consists of imprisoned osteocytes and lacunae with radiating canaliculi. At the outer surface of the bone, however, note the density of basophilic cells against the bone, forming an epithelioid membrane of osteoblasts. These cells lay down new matrix and fibers, thus becoming entrapped as osteocytes. Continued action of osteoblasts on the outer surface adds to the thickness of the bone. Look on the inner surface of the spicules of bone for multinuclear osteoclasts, or bone-resorbing cells (A-15 [10x, 20x, 40x-labeled] [40x, 40x]). These cells have clusters of nuclei and tend to be acidophilic. Inner resorption and outer deposition result in overall enlargement of the bones.Intramembranous Bone Formation Image Gallery
Intramembranous Bone Formation Table of Identifications
| Row | Structure | Abbreviation | Optimal Stain | Representative Section | Note |
|---|---|---|---|---|---|
| 1 | Skin | (none) | H&E | |
|
| 2 | Skull | (none) | H&E | |
|
| 3 | Brain | (none) | H&E | |
|
| 4 | Osteocyte | (none) | H&E | |
|
| 5 | Osteoblast | (none) | H&E | |
|
| 6 | Dense Connective Tissue | DCT | H&E | |
|
| 7 | Periosteum | P | H&E | |
|
| 8 | Osteoclast | Oc | H&E | |
Top of page
Enchondral Bone Formation
This type of bone is formed in a pre-existing cartilage model as the name implies. The cartilage must first be removed and then the bone laid down. The first indication of this process is the hypertrophy of the hyaline cartilage cells in the midshaft of the cartilagenous long "bone." These cells become enlarged and the matrix a lighter staining blue. At the same time, osteoprogenitor cells in the perichondrium begin laying down bone matrix to form a bone collar around the outside of the cartilage model. This gives support during bone formation. Blood vessels and mesenchyme, called periosteal buds, enter through the bone collar into the primary ossification center in the midshaft of the bone. Ossification then occurs within the eroded areas and a similar process occurs in the epiphysis. Look for some of these early stages of bone formation on slide A-12 (fetal finger [2.5x-labeled, 10x-labeled, 10x, 20x-labeled, 40x]) or A-11 (fetal foot [2.5x, 10x-labeled, 20x, 40x] [2.5x, 2.5x, 2.5x-labeled, 10x, 10x]). A primary ossification center occupies the central shaft of the bone (the diaphysis), while each end of the bone (epiphysis) still exists as hyaline cartilage. Look at the transition zone which is characterized by a ragged-looking tissue, surrounded by marrow spaces. On its cartilaginous side, some distance away from the transition, chondrocytes are small and rather flattened (Reserve or Resting Zone). Toward the zone of change, the lacunae and cells become more numerous and closely packed, occurring in nests. The clusters of cells are arranged in indistinct columns in the axis of the bone (Proliferative Zone). At the transition point between bone and cartilage, the chondrocytes swell (Hypertrophic Zone), and apparently die, whereupon their lacunae break open and are invaded by marrow tissues and blood vessels. Spicules of matrix between the columns of dying cells become calcified cartilage (Calcification Zone). Osteoblasts cover the surface of calcified cartilage spicules and deposit bone (more darkly stained than the calcified cartilage): this is the ragged-looking tissue referred to above. Further osteogenesis in this area involves the gradual removal of this primary bone (that is, the bone laid down around calcified cartilage matrix) by osteoclasts and replacement by bone deposited around the invading blood vessels (Zone of Resorption). Note that while cartilage is being converted to bone internally, the fibrous membrane around the skeletal element has changed from perichondrium to periosteum and has deposited bone along the surface of the diaphysis. This periosteal bone (also called the bony collar) gives support to the bony shaft at a time when the shaft internally is very weak because of the invasion of marrow tissue and the conversion of cartilage to bone. (Events which occur before the state represented by this slide include the formation of a primary marrow cavity and the invasion of a marrow bud from the perichondrium. These prior events should be reviewed in the textbook in order to understand what is seen on this slide properly). Remember that appositional growth is on top of an existing structure while interstitial growth is growth within tissue, e.g. replication of chondrocytes.Enchondral Bone Formation Image Gallery
Enchondral Bone Formation Table of Identifications
| Row | Structure | Abbreviation | Optimal Stain | Representative Section | Note |
|---|---|---|---|---|---|
| 1 | Transition Zone | (box) | H&E | |
|
| 2 | Hypertrophy | (none) | H&E | |
|
| 3 | Calcification | (none) | H&E | |
|
| 4 | Resorption | (none) | H&E | |
|
| 5 | Bone | (none) | H&E | |
|
| 6 | Reserve | (none) | H&E | |
|
| 7 | Proliferation | (none) | H&E | |
Top of page
Secondary Center of Ossification
Examine slide A-9 ([2.5x-labeled, 10x, 20x-labeled, 40x] [2.5x] [2.5x-labeled] [2.5x] [2.5x, 10x, 20x, 40x-labeled]). This is a section through the knee joint of a rabbit. Can you identify the distal portion of the femur, the patella and the tibia? Some sections may include part of the ankle joint as well. Note that the ends of the bones are still composed of hyaline type cartilage. Try to identify the different zones of cartilage (reserve, proliferating, hypertrophic) as they transition into bone (enchondral ossification). Also note that the cartilaginous end of the femur has a secondary center of ossification in the middle of the cartilage. This proceeds by ingrowth of blood vessels into the cartilage, bringing osteoblasts. Try to identify the blood vessels, new bone, and bone marrow within the center of the cartilage. In humans, this secondary center of ossification appears at the end of bones at various ages; in the proximal femoral head it is present near the time of birth and continues to ossify throughout childhood. The secondary center of ossification of the distal femoral condyle (which is on slide A-9) appears somewhat later after birth. The exposed surface of the remnant of the cartilage model becomes the articular surface of the joint; the portion of the cartilage model remaining near the shaft of the developing bone becomes the physis or growth plate, which continues to undergo enchondral ossification, contributing to lengthening of the bone, until growth stops after puberty. The growth plate (physis) separates two compartments – the epiphysis, which is between the growth plate and the articular cartilage, and the metaphysis, which is on the other side of the growth plate, towards the shaft of the bone. When all the cartilage (except for the articular surface) has been converted to bone, growth stops, and the growth plates are said to be "closed". Then there will no longer be an anatomic barrier between the epiphysis and metaphysis -only bone.Secondary Center of Ossification Image Gallery
Secondary Center of Ossification Table of Identifications
| Row | Structure | Abbreviation | Optimal Stain | Representative Section | Note |
|---|---|---|---|---|---|
| 1 | Joint Cavity | JC | H&E | |
|
| 2 | Articular Cartilage | AC | H&E | |
|
| 3 | Secondary Ossification Center | Os | H&E | |
|
| 4 | Endochondral Bone | EB | H&E | |
|
| 5 | Epiphyseal Plate | EP | H&E | |
|
| 6 | Periosteum | P | H&E | |
|
| 7 | Hypertrophic Cartilage Cell | HC | H&E | |
|
| 8 | Osteoclast | OC | H&E | |
|
| 9 | Red Blood Cell | RBC | H&E | |
Top of page
Joint space and synovium
The joint space is defined by fibrous ligaments forming a dense capsule, and is lined by synovium, present as delicate vascular tissue which extends along the surface of the articular cartilage in a papillary fashion (slide A-9 [1x] [2.5x, 10x, 20x, 40x] [2.5x-labeled, 10x, 20x, 40x]). The synovium is lined by two kinds of cells – secretory and phagocytic, although these are not easily distinguished from one another. You should be able to identify the synovium within the joint space, and see the lining, which covers the loose fibrous-vascular network underneath. The synovium is important in producing synovial fluid, which lubricates the joint; synovial fluid also nourishes the cartilage, which in adults is completely avascular. The knee joint is a complicated joint, which allows movement in several planes. In addition to the fibrous capsule, there are additional ligaments between the bones, adding to flexibility and stability of the structure as a whole.Joint Space and Synovium Image Gallery
Joint Space and Synovium Table of Identifications
| Row | Structure | Abbreviation | Optimal Stain | Representative Section | Note |
|---|---|---|---|---|---|
| 1 | Joint Capsule | (none) | H&E | |
|
| 2 | Synovium | (none) | H&E | |
|
| 3 | Joint Cavity | (none) | H&E | |
|
| 4 | Articular Cartilage | (none) | H&E | |
Top of page
Chapter Eight Review
Review of Slides
Review of Identifications
| Row | Structure | Abbreviation | Optimal Stain | Representative Section | Note |
|---|---|---|---|---|---|
| 1 | Dense Connective Tissue | DCT | PAS, H&E | |
|
| 2 | Perichondrium | P | PAS | |
|
| 3 | Growing Cartilage | GC | PAS | |
|
| 4 | Chondroblast | Cb | PAS | |
|
| 5 | Mature Chondrocyte | C | PAS, H&E | |
|
| 6 | Chondrocyte Nucleus | (none) | PAS | |
|
| 7 | Lacuna | (none) | PAS, H&E | |
|
| 8 | Cell Nest (Isogenous Group) | (none) | PAS | |
|
| 9 | Ground Substance | (none) | PAS | |
|
| 10 | Hyaline Cartilage | (none) | H&E | |
|
| 11 | Pseudostratified Columnar Epithelium | (none) | H&E | |
|
| 12 | Fibroblast | (none) | H&E | |
|
| 13 | Formative Chondrocyte | (none) | H&E | |
|
| 14 | Fibrous Perichondrium | Pf | H&E | |
|
| 15 | Cellular Perichondrium | Pc | H&E | |
|
| 16 | Intervertebral Disk | (none) | H&E | |
|
| 17 | Fibrocartilage | (none ) | H&E | |
|
| 18 | Bone | (none) | H&E | |
|
| 19 | Bone Marrow | (none) | H&E | |
|
| 20 | Interterritorial Matrix | IM | H&E | |
|
| 21 | Territorial Matrix | TM | H&E | |
|
| 22 | Haversian Canal | HC | Ground | |
|
| 23 | Interstitial Lamellae | IL | Ground | |
|
| 24 | Osteocyte Lacuna | L | Ground | |
|
| 25 | Osteon | O | Ground | |
|
| 26 | Volkmann's Canal | VC | Ground | |
|
| 27 | Trabecular Bone | (none) | H&E | |
|
| 28 | Endosteum | (none) | H&E | |
|
| 29 | Endosteal Cell | (none) | H&E | |
|
| 30 | Osteocyte | (none) | H&E | |
|
| 31 | Skin | (none) | H&E | |
|
| 32 | Skull | (none) | H&E | |
|
| 33 | Brain | (none) | H&E | |
|
| 34 | Osteoblast | (none) | H&E | |
|
| 35 | Periosteum | P | H&E | |
|
| 36 | Osteoclast | Oc | H&E | |
|
| 37 | Transition Zone | (box) | H&E | |
|
| 38 | Hypertrophy | (none) | H&E | |
|
| 39 | Calcification | (none) | H&E | |
|
| 40 | Resorption | (none) | H&E | |
|
| 41 | Reserve | (none) | H&E | |
|
| 42 | Proliferation | (none) | H&E | |
|
| 43 | Joint Cavity | JC | H&E | |
|
| 44 | Articular Cartilage | AC | H&E | |
|
| 45 | Secondary Ossification Center | Os | H&E | |
|
| 46 | Endochondral Bone | EB | H&E | |
|
| 47 | Epiphyseal Plate | EP | H&E | |
|
| 48 | Hypertrophic Cartilage Cell | HC | H&E | |
|
| 49 | Osteoclast | OC | H&E | |
|
| 50 | Red Blood Cell | RBC | H&E | |
|
| 51 | Joint Capsule | (none) | H&E | |
|
| 52 | Synovium | (none) | H&E | |
Top of page
Comments
Top of page -- AshleyLPistorio - 27 May 2007Edit | Attach | Print version | History: r2 < r1 | Backlinks | View wiki text | More topic actions
Topic revision: r2 - 20 Jun 2015, LorenEvey
- Epithelium
- Connective Tissue
- Muscle
- Nervous Tissue
- Cardiovascular System
- Skin Appendages and Sensory Receptors
- Lymphatic System
- Cartilage and Bone
- Respiratory System
- Peripheral Blood and Bone Marrow
- Oral Cavity and Salivary Glands
- Esophagus and Gastrointestinal Tract
- Pancreas, Liver, and Gall Bladder
- Endocrine Organs
- Male Reproductive System
- Female Reproductive System
- Urinary System
 Copyright © by the contributing authors. All material on this collaboration platform is the property of the contributing authors.
Copyright © by the contributing authors. All material on this collaboration platform is the property of the contributing authors. Ideas, requests, problems regarding Medical Histology? Send feedback